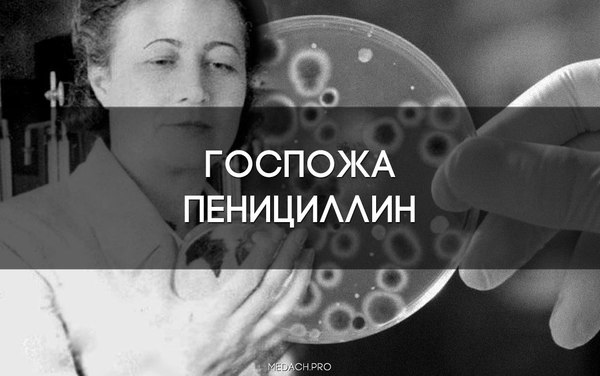

Госпожа Пенициллин
Пианист коснулся клавиш – и нарядный, по случаю выпускного, зал гимназии наполнили чарующие звуки «Сентиментального вальса». Замерев у окна, девушка сквозь слезы шептала: «Как же так? Нелепая смерть. Ведь он гений! И в самом расцвете…»
Эта история началась в 1915 году в городе Новочеркасске. Выпускница Мариинской женской гимназии Зинаида Ермольева, услышав на выпускном балу музыку обожаемого Чайковского, вспомнила о его биографии, томик которой лежал сейчас дома под её подушкой. История смерти великого композитора сильно впечатлила юную барышню. Представляя себе, как измученное холерой тело погружают в яму, залитую известью, Зинаида твердо решила стать врачом и победить эту страшную инфекцию.
В 1921 году Зинаида оканчивает медицинский факультет Донского университета. Спустя год в Ростове-на-Дону вспыхивает эпидемия холеры и Ермольева впервые встречается со своим главным врагом. И сразу показывает всем, чего она стоит: выделив из организма больного холероподобный вибрион, она, чтобы доказать его патогенность и причастность к возникновению вспышки – ставит эксперимент на себе. 24-летняя девушка выпивает суспензию вибрионов и у нее развивается тяжелое заболевание. В протоколе опыта она пишет: «Эксперимент, который едва не кончился трагически, доказал, что холероподобные вибрионы, находясь в кишечнике человека, могут вызывать заболевание, схожее с истинной холерой». Далее Ермольева начинает разрабатывать микробиологические методы диагностики холеры, а так же методы профилактики этого заболевания. Одним из итогов работы стала разработка метода обеззараживания питьевой воды остаточным хлором, который используется и по сей день.
Талантливой девушке, буквально вчерашней студентке, поручают заведовать бактериологическим отделением Северо-Кавказского бактериологического института, параллельно она ассистирует на кафедре микробиологии Северо-Кавказского университета. Но уже в 1925 году она возглавила отдел биохимии микробов в Биохимическом институте в Москве. Здесь Ермольева встречает своего первого мужа - Льва Зильбера, впоследствии выдающегося бактериолога, создателя школы медицинской вирусологии и вирусной теории рака. Свои «медовые месяцы» они проводят, работая в Институте им. Пастера во Франции и Институте им. Коха в Германии.
В 30-е годы Ермольева работает с лизоцимом и, в частности, разрабатывает способ консервирования икры с его помощью, что было чрезвычайно актуально на тот момент. В 1935 г. ей была присуждена докторская степень, а в 1939 г. – звание профессора.
В 1939 году в Афганистане возникла вспышка холеры. Естественно, Ермольева не могла оставить своего главного врага и отправилась в Среднюю Азию. Здесь она с успехом испытала разработанные ей препараты холерных бактериофагов, используя их в качестве профилактики на пограничных постах.
И как же ей пригодился этот опыт, когда угроза эпидемии холеры возникла во время Сталинградской битвы. Эшелон с препаратами бактериофага, на котором прибыла Ермольева, был разбомблен. В подвалах полуразрушенного города, где шли непрекращающиеся бои, эта женщина смогла наладить производство бактериофагов и обеспечить ими городское население и армейские части. Ежедневно препараты бактериофагов получали около 50 тысяч человек. Это был беспрецедентный случай в истории медицины. Получив за это Сталинскую премию, Ермольева приобрела на неё самолет и передала армии. Истребитель назвали ей именем: «Зинаида Ермольева».
Но с именем этой женщины, в первую очередь, ассоциируется, конечно же, пенициллин. Пенициллин, как известно, открыл в 1929 году Флеминг. Он так и не смог выделить его в чистом виде – это сделали только в 1941 году Флори и Чейн. Но это в Англии. А в СССР то же самое смогла сделать Ермольева. Она не только выделила пенициллин в чистом виде, но и смогла наладить его производство. В 1944 году в СССР прибыл профессор Флори. Он привез с собой образец пенициллина и его сравнили с советским – наш оказался эффективнее, а англичане прозвали Ермольеву «Госпожа Пенициллин». В том же году Ермольева отправляется на фронт для клинических испытаний этого препарата, которые он, как известно, с успехом прошел.
Я могу бесконечно долго рассказывать о заслугах этой женщины. Я искренне восхищаюсь ей. Поставить эксперимент на себе в 24 года, стать доктором наук в 37, совершить сотню открытий, наладить производство препаратов в условиях войны, подарить армии именной истребитель… О такой жизни можно писать книги и снимать кино. Вениамин Каверин написал замечательный роман «Открытая книга», дважды экранизированный в 70-х. Героиня романа – Татьяна Власенкова – списана Кавериным с Зинаиды Ермольевой.
Приведу еще один пример, который, как нельзя лучше, показывает силу этой женщины и преданность своему делу. У Ермольевой было 2 мужа. Зильбер, упоминавшийся выше, с которым она довольно быстро рассталась, и Алексей Захаров. Оба были микробиологами. Оба были репрессированы. В годы войны оба сидели и Ермольева ходатайствовала лично Сталину об освобождении под предлогом их важности для работы. Ей предложили выбор: освободить одного из. Ермольева выбрала бывшего мужа – Зильбера. На вопрос: «Почему?», она ответила: «Он нужен науке».
Источник:
Чаурина Р. А. Зинаида Виссарионовна Ермольева (1898—1974) «Биология»

Наука | Научпоп
9.6K постов83.1K подписчиков
Правила сообщества
Основные условия публикации
- Посты должны иметь отношение к науке, актуальным открытиям или жизни научного сообщества и содержать ссылки на авторитетный источник.
- Посты должны по возможности избегать кликбейта и броских фраз, вводящих в заблуждение.
- Научные статьи должны сопровождаться описанием исследования, доступным на популярном уровне. Слишком профессиональный материал может быть отклонён.
- Видеоматериалы должны иметь описание.
- Названия должны отражать суть исследования.
- Если пост содержит материал, оригинал которого написан или снят на иностранном языке, русская версия должна содержать все основные положения.
- Посты-ответы также должны самостоятельно (без привязки к оригинальному посту) удовлетворять всем вышеперечисленным условиям.
Не принимаются к публикации
- Точные или урезанные копии журнальных и газетных статей. Посты о последних достижениях науки должны содержать ваш разъясняющий комментарий или представлять обзоры нескольких статей.
- Юмористические посты, представляющие также точные и урезанные копии из популярных источников, цитаты сборников. Научный юмор приветствуется, но должен публиковаться большими порциями, а не набивать рейтинг единичными цитатами огромного сборника.
- Посты с вопросами околонаучного, но базового уровня, просьбы о помощи в решении задач и проведении исследований отправляются в общую ленту. По возможности модерация сообщества даст свой ответ.
Наказывается баном
- Оскорбления, выраженные лично пользователю или категории пользователей.
- Попытки использовать сообщество для рекламы.
- Фальсификация фактов.
- Многократные попытки публикации материалов, не удовлетворяющих правилам.
- Троллинг, флейм.
- Нарушение правил сайта в целом.
Окончательное решение по соответствию поста или комментария правилам принимается модерацией сообщества. Просьбы о разбане и жалобы на модерацию принимает администратор сообщества. Жалобы на администратора принимает и общество Пикабу.